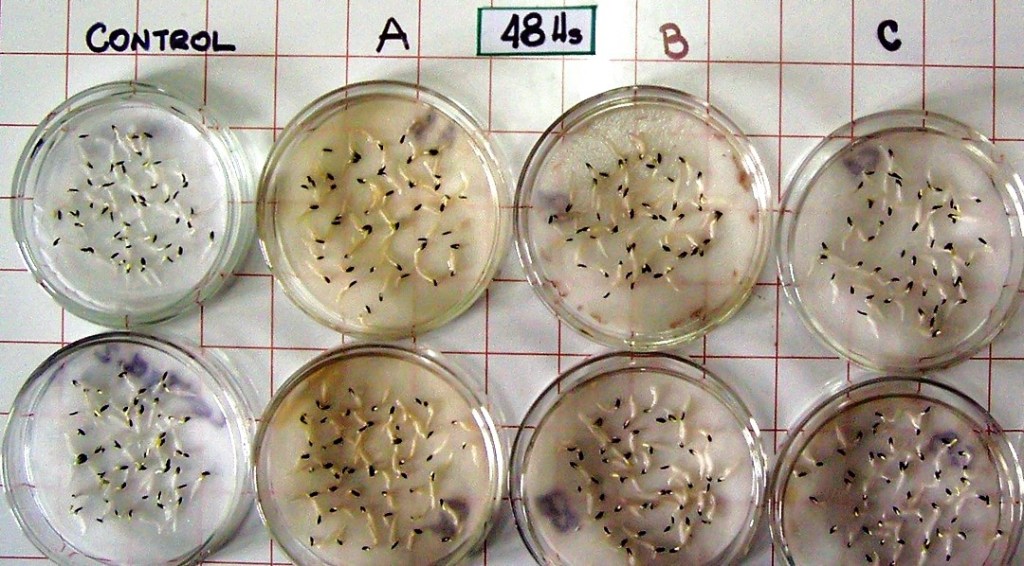

Investigadores de la Facultad de Agronomía de la UBA y de la Facultad de Ciencias Químicas de la UNC investigan sobre las posibilidades que ofrece la cáscara de maní para la mejora de suelos, mediante la técnica de pirólisis. En las pruebas lograron mejores rendimientos en los cultivos con los que experimentaron.
Por Por Matías Alonso
La Argentina produce más de un millón de toneladas de maní al año –la gran mayoría en la provincia de Córdoba– y buena parte de la cosecha se exporta, en muchos casos tras pasar por procesos como la extracción de su cáscara, que deja con un residuo que representa el 25% del peso del producto. La cáscara del maní está tomando cada vez más importancia para su aprovechamiento en otras industrias y uno de sus usos más comunes es como combustible para alimentar los hornos en los que se seca el maní recién cosechado.
Un grupo de investigación de la Facultad de Agronomía de la Universidad de Buenos Aires (FAUBA) está desarrollando un nuevo proceso para convertir a este desecho en biocarbones con diferentes aplicaciones para el agro, como el mejoramiento de suelos. Con esta finalidad, están investigando con diferentes métodos de pirólisis, proceso mediante el cual la cáscara de maní se inserta en un horno sin la presencia de oxígeno.
La doctora en Ciencias Agropecuarias Mariana Silva, del Instituto de Investigaciones en Biociencias Agrícolas y Ambientales (INBA) de la FAUBA y el CONICET, explica que usan distintas clases de pirólisis: rápida, lenta y analítica. «De eso depende la rampa de aumento de temperatura y hará variar las condiciones de pirólisis. También usamos otras técnicas, como microondas. La pirólisis analítica consiste en utilizar una porción muy pequeña del material a analizar, como la punta de un alfiler, adentro de un pirolizador, y eso se quema a muy alta temperatura y pasa totalmente a gas, lo que permite hacer la caracterización de todos lo compuestos que tiene, saber si una planta pertenece a tal especie o no, o si se han alterado productos».
Foto: INBA.
Mediante la pirólisis se obtiene el biocarbón pero también gases y aceites que pueden tener diferentes usos en la industria, como biocombustibles, inclusive con el aprovechamiento de otras plantas. «En otros de los trabajos que estuvimos haciendo estuvimos probando con una planta nativa de Córdoba, la Flourencia oolepis, que tiene un compuesto que es derivado del bisaboleno y se puede usar para combustibles para motores jet. También se puede hacer extracto de algún fenol que se usa para darle fragancia a los productos de limpieza».
Los biocarbones obtenidos permitieron estimular el crecimiento vegetal, según explica Silva: «Hicimos ensayos en los que pusimos los carbones en agua, los dejamos una noche y después se usó el agua para sembrar en cápsulas de petri unas semillas de lechuga. Las medimos a las 24, 48 y 72 horas y se comparó con otras semillas que se regaron con agua normal y ahí se vio que la cáscara del biocarbón estimulaba la enlongación de tallos y raíces, obteniendo resultados de entre un 50 y un 100% más grandes que en el grupo de control».
El proceso de pirólisis, una vez que terminen con la validación de las pruebas en campo, podrá ser realizado por el productor agropecuario que tenga un horno que permita llevarlo a cabo. Además del quemado para los procesos de secado, la cáscara de maní también se reutiliza para la producción de placas de aglomerado, que ofrece un precio un 20% menor al de las placas que utilizan madera.
De la investigación, que fue publicada en la revista científica Springer Nature, participan Silva y Ana Scopel, del INBA, y Laura Moyano, del Departamento de Química Orgánica de la Facultad de Ciencias Químicas de la Universidad Nacional de Córdoba, donde cuentan con los hornos para la realización de las pruebas experimentales.
Fuente: TSS
